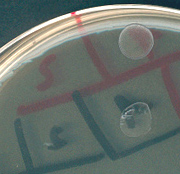

Hormis les dénominations bactériennes
| A
| B
| C
| D
| E
| F
| G
| H
| I
| J
| K
| L
| M
| N
| O
| P
| Q
| R
| S
| T
| U
| V
| W
| X
| Y
| Z
|
Bile
Ancien test de lyse des pneumocoques ou mieux incorporé dans un milieu gélosé ou liquide pour le diagnostic d'orientation de certains entérocoques. Le caractère "croissance en présence de bile" est associé à celui de l' "utilisation de l'esculine"

Retour
|
|
|
|
|